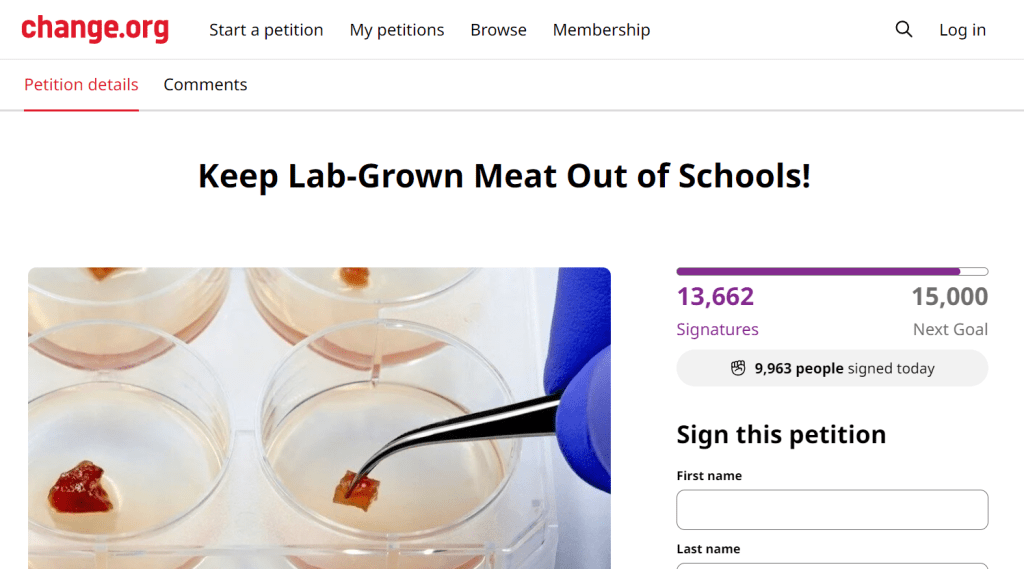

Lab-Grown Meat
There’s an online petition to stop lab-grown meat from being served in schools.
When I heard about it, I needed to know more.
The petition lists reasons why serving lab-grown meat in schools is a bad idea. These reasons are kind of boring, so I scrolled down to where people have posted videos of themselves explaining why they signed the petition.
I watched a few. The gist of them was, “Lab meat is weird. Things I don’t understand are weird. I don’t like weird things. So I don’t want my kids to eat lab-grown meat.”
That was good enough for me, so I signed the petition to keep the weird lab meat away from the kids.
A while later I got to thinking, “Maybe I was too rash.”
I’ve long pondered the moral grey zone preceding constructive discourse regarding cannibalism.
As a person who’s studied enough moral philosophy to seem smart to anybody as stupid or stupider than me, the whole thing about synthesized meat and cannibalism was something I realized I needed to philosophize about.
There’s a stigma surrounding cannibalism. Not only cannibalism, but the consumption of monkey flesh, as well. Somehow, they seem to go hand-in-hand.
It’s forbidden, yet, we’ve all wondered what either human and/or monkey flesh would taste like. It’s mostly the moral stigma that’s kept us from pursuing it. Well, that, and a lack of readily available monkeys in many climes.
But, with lab-grown meat, there’s little to no harm. The flesh is simply grown in a dish. Except for the minor extraction of meat that serves as the kick starter for the strain, there is really no harm. Heck, even if the starter-flesh is extracted from a living person, it’s less than what’s lost taking an average shit.
Of course, the general acceptance of lab-cultured meat has it’s problems.
It opens up a can of worms – morally, socially, economically, even politically.
Main principle: If there is no harm done in culturing meat, then there is no harm, even when the meat is of human or simian origin.
If we can accept this moral proposition, just think of the possibilities.
Consider being able to eat a steak cultured from the meat of a favorite celebrity.
See, that’s how it ties into politics, society and the economy.
Politically – we must get the okay. It must be okayed by our leaders as ethical. And they must pave the way for it to be regulated.
Socially – even with political approval, there may still exist a social stigma which we, as a society, must destigmatize. This, of course, is done through popular culture and our political and religious leaders assuring us it’s okay.
Economically – this is Capitalism 101. The undeveloped market for meat synthesized from celebrities (e.g. Kanye West hamburger or Kardashian rump roast). Economic growth and prosperity is the main angle here, though there will necessarily exist a counter-contingent representing the entrenched interests of traditional meats.
There are huge profits to be made, not only for Kanye and the Kardashians, but common folks as well. All of it points to an overwhelming social good.
“Imagine all the jobs from culturing, processing, packaging, shipping and selling celebrity meat,” the politician can declare. “Jobs! Jobs! Jobs for all!!!!”
“Succulent,” he can then attest, eating a slice of lab-cultured steak from Rosie O’Donnell’s flank. He smiles as he chews, while Rosie takes a butter drenched and expertly seasoned bite of herself.
“So flavorful,” Rosie says to an applauding crowd. “And tender.”
Of course, as with any grade of meat, there are grades of celebrity, too. Tom Cruise may be USDA Prime, whereas Steven Segal is USDA Select. Tom Cruise may be Ruth’s Chris, whereas Segal is Ponderosa or Golden Corral’s Signature Sirloin. Or Clint Eastwood as the patty meat in Burger King’s Big Western King, topped with onion rings, 3 slices of pepper jack cheese, Frito’s and BBQ sauce.
The marketing opportunities are vast. And there’s much economic and political gain to be had.
In opposition, there’s the conservative stance against most things new -like synthesized, lab-grown meat. Opposition to anything new because it’s weird. And being weird is reason enough to oppose it.
A political stance objecting to synthesized meat could be salient. It could be the untapped issue that decides an election.
Donald Trump, for example, even has the history of Trump Steaks to lend this position credibility.

Trump has the history of endorsing real (non-lab) meat with Trump Steaks. It would be the perfect opportunity to resurrect that failed venture. The perfect opportunity to claim that it never failed. It was only, in fact, suspended until the time was right for its perfect revitalization.
Picture Trump chewing a morsel of synthesized Rosie O’Donnell or Ben Affleck meat, spitting it out and claiming it tastes like shit.
“Nothing like a real steak. A real beef Trump Steak. Grain-fed. No lab. So delicious.”
What a glorious PR stunt. Trump eating a real Trump Steak with ketchup, french fries and Diet Coke, alongside his everyman sidekick, Kid Rock, shotgunning a PBR while torching a case of “perverted” Rosie O’Donnell lab meat with a flame thrower as an ecstatic crowd chants, “USA!!!USA!!!USA!!!”
Real meat is the stuff of real men. Sportsmen. Patriots. Crusaders for some vague notion of FREEDOM. Men with respect for the law and authority, but only when it suits them. Gun and monster truck men. Men who dream of destruction and crave aggression. Men who love the outdoors as much as they fear the big city’s streets. Men who fear the black or gay man they don’t know more than any bear or wild, charging boar. Men far more proud of their ability to drink, hunt, grill and wave the flag than any amount of wisdom or education they’ve acquired or attained. In other words, conservative, gung-ho macho men.
These are the “BBQ Beer Freedom” men. The “Sun’s Out? Guns Out!” men. These are the men living by the Triple B tenets of “Bullets, Beer and Barbeque”.

Rugged, sometimes jacked, tattooed men, secure enough in their identities and positions in the social hierarchy, they exclaim their allegiances through hoodie prints and vanity plates on their giant trucks. Men, hyper-secure in their identities, who, like goth kids or Juggalos, make a display of these identities through every aspect of their living. Men still worshipping at the alters of the mesomorphic action heroes they grew up with. Men conditioned to feel empathy and the exercise of intellect as annoying weaknesses. Men who power up huffing the vapor of diesel fuel, burnt gunpower and the smoke of smoldering hickory chips. These are the real men of meat – the antithesis of the groveling, weak-kneed soy boy.
This contingent will be a real obstacle to progress, clinging to the fetish for real (non-synthesized) meat as tightly as they cling to their guns, trucks and heroic conceptions of themselves. Any move toward normalization of lab meat will be met with fierce social and political opposition. Arguments castigating lab meat as anti-American, unconstitutional, perverse, Communistic, unsafe, and unholy, among others, are certain to make their way into mainstream political discourse – with corndogs, SPAM and Chicken McNuggets held as sacred as Old Glory, the Bible and The Right To Bare Arms.
But they are only one front of the political attack.
For, although no animal (human or otherwise) is harmed from meat cultured in the lab, that flesh is still the property and product of the animal from which it was harvested. And, without the consent of the animal for its flesh to be replicated, the act of reproduction is inherently and necessarily exploitative. Animals, after all, in a just world, have just as might right to autonomy as any other being.
There will be many hurdles.
My moral conscience guides me in one direction. Yet, I’m a hedonist, too. I am greedy, not only for human and monkey meat, but for money, fame and power, as well.
Which causes me to consider: How to exploit? How to gain?
I could start a Real Meat movement. We could be the activists for Real Meat in Schools. I could administer it. I could ask for sponsors and donations. I believe BarS, Perdue Farms and Hormel Foods (parent to SPAM) would be on board. They would pay me handsomely to lobby for their interests. I could collect lots and lots of money from parents scared their children will be fed lab-grown human or monkey meat at school. Or meat grown from worms, homosexuals, rats or brown people. I will accept, as my job, stoking terror in these parents. I will assure them their panic is reasonable and justified. I will assure these parents that, with enough money to fund my crusade, I will be the one to stop the insanity. My movement will save their children. The money will flow. The cost of administering the movement will soar. I will become filthy rich. Rich enough to hire a lawyer to ensure all my finances are legit enough to keep me rich and out of prison. Those who I lobby for and all the frightened parents will pay me through the proper channels. I will pay the politicians through the proper channels. And they will pay me. A perfect, yet complex, symbiosis. It seems like a complicated game, requiring much savvy to navigate. A very savvy lawyer (or many) to rely upon, for sure.
Not only lawyers, but a team of public relations experts will be needed too. We’ll need slogans and graphics referencing guns and the flag and meat and FREEDOM to plaster on shirts, hats, flags, license plates and stickers. And, for the women, the same designs and slogans, only printed on pink or camo with “chick” added for a touch of edgy, feminine spice.
And, with their expertise in advertising, we’ll know exactly where to target our bourgeoning subculture of Real Meat advocacy. Target them with ads and commercials as parasites of algorithms, ostensibly created to serve a greater good. A bombardment of ads and commercials selling our shit as proof of allegiance to the cause. A blitzkrieg of social media reminders of the righteous cause to which we’re subscribed.
Then, I will endorse a presidential candidate. The candidate who endorses real meat. And he, in turn, will endorse me and my movement.
With his endorsement, I will then be famous, as well as rich.
We will sermonize to our constituents and disciples about the horrors and evils of lab-grown meat. We will preach through dog whistles and coded jargon to identify the real culprits of the abomination of lab meat and their sinister plan behind it all. We will tell them that lab-grown meat will turn their children, families, friends, neighbors, church and country into something as weird as the lab-grown meat itself. Something as weird as the gays, blacks, foreigners and immigrants they tell themselves they don’t fear. Or, of whose courage, certainty, or genuine commitment to genuine convictions they are secretly jealous. People they secretly fear, regardless of race, religion, sexuality, or land of birth, because they may be better people than themselves. A closeted shame that these “others” may be more courageous in their tolerance and convictions than the ones obnoxiously displaying their courage on rear windows and shirt sleeves.
Exploiting their frailties of ego and social status is the key.
Exploiting fear of the unknown is paramount.
And from all this, the money and power will flow.
With my newfound fame and fortune, I will buy a plane and a private island. And on that island will be a laboratory. A laboratory that grows meat.
A lab on a private island, far beyond the reach of most jurisdictions of justice.
A private island with a lab in which I may grow any kind of meat.
